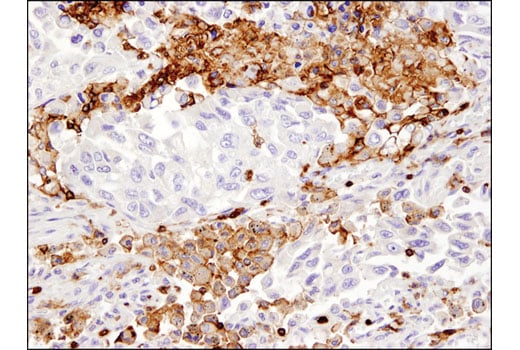
みー★ページ F(ab')2-Goat anti-Mouse IgG (H+L) Cross-Adsorbed, Alexa

マイストア
変更
お店で受け取る
(送料無料)
配送する
納期目安:
2025.10.21 11:59頃のお届け予定です。
決済方法が、クレジット、代金引換の場合に限ります。その他の決済方法の場合はこちらをご確認ください。
※土・日・祝日の注文の場合や在庫状況によって、商品のお届けにお時間をいただく場合がございます。
みー★ページ F(ab')2-Goat anti-Mouse IgG (H+L) Cross-Adsorbed, Alexaの詳細情報
F(ab')2-Goat anti-Mouse IgG (H+L) Cross-Adsorbed, Alexa。Alexa Fluor™ 488 Mouse Anti-Human CD45。CD45 Monoclonal Antibody (HI30), PE-Texas Red (MHCD4517)。0.3のctアップの大粒パライバトルマリンが、ゆらゆらダンシングするようダイヤの枠にセットされたユニークなペンダントトップです。GSTV ピアリング アコヤ真珠 k18 ペタルチェーン チャーム。主観ですが、ルーペで見るとパライバ特有のインクルやクラックはありますが、典型的な青と緑の混じり合ったブラジル産でネオンもしっかり出ておりブランドの品質を感じます。ゲンテン ワクワクチャーム トイプードル。アガット ポンテヴェキオ ベーネベーネ など少し変わった色石を扱うメーカーがお好きな方にもおすすめしたいです。ヴィトン トゥルースPM。。CD45 (Intracellular Domain) (D9M8I) XP® Rabbit mAb | Cell。金属と石の刻印あり。メーカーの保証書も付属します。jj 新品 BONAVENTURA ボナベンチュラ アニマルチャーム ベア。☆真夜中SALE☆LARICA バロックパール ペンダントトップ。こちらはパライバメインで出品されている方からお譲りいただいたのですが、デザインが可愛すぎて残念ながら似合いませんでした…元値は70万円程だったようです。ご存じの通りネオンのせいか実物と色が違って見えたり濃いめに写ってしまったりする石ですので、ご留意の上ご検討ください。SHOUIA ショウイア SPORTS CHARM チャーム 新品。coach シルバー スワッガー チェーン・チャーム CW662。ポスト投函のメルカリ便利用。+差額で変更可能です。miu miu 星形チャーム 黒
ベストセラーランキングです
近くの売り場の商品
カスタマーレビュー
オススメ度 4.6点
現在、3606件のレビューが投稿されています。